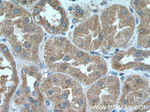
Prohibitin Antibody in Immunohistochemistry (Paraffin) (IHC (P))
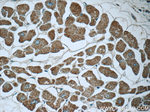
Prohibitin Antibody in Immunohistochemistry (Paraffin) (IHC (P))

Search
Proteintech
Prohibitin Monoclonal Antibody (4D3G5)
{{$productOrderCtrl.translations['antibody.pdp.commerceCard.promotion.promotions']}}
{{$productOrderCtrl.translations['antibody.pdp.commerceCard.promotion.viewpromo']}}
{{$productOrderCtrl.translations['antibody.pdp.commerceCard.promotion.promocode']}}: {{promo.promoCode}} {{promo.promoTitle}} {{promo.promoDescription}}. {{$productOrderCtrl.translations['antibody.pdp.commerceCard.promotion.learnmore']}}
产品信息
60092-1-IG
种属反应
宿主/亚型
分类
类型
克隆号
抗原
偶联物
形式
浓度
规格
纯化类型
保存液
内含物
保存条件
运输条件
产品详细信息
Immunogen sequence: MAAKVFESI GKFGLALAVA GGVVNSALYN VDAGHRAVIF DRFRGVQDIV VGEGTHFLIP WVQKPIIFDC RSRPRNVPVI TGSKDLQNVN ITLRILFRPV ASQLPRIFTS IGEDYDERVL PSITTEILKS VVARFDAGEL ITQRELVSRQ VSDDLTERAA TFGLILDDVS LTHLTFGKEF TEAVEAKQVA QQEAERARFV VEKAEQQKKA AIISAEGDSK AAELIANSLA TAGDGLIELR KLEAAEDIAY QLSRSRNITY LPAGQSVLLQ LPQ (1-272 aa encoded by BC013401)
靶标信息
Prohibitin is from an evolutionarily conserved gene that is ubiquitously expressed. It is thought to be a negative regulator of cell proliferation and may be a tumor suppressor. Mutations in PHB have been linked to sporadic breast cancer. Prohibitin is expressed as two transcripts with varying lengths of 3' untranslated region. The longer transcript is present at higher levels in proliferating tissues and cells, suggesting that this longer 3' untranslated region may function as a trans-acting regulatory RNA.
仅用于科研。不用于诊断过程。未经明确授权不得转售。
生物信息学
蛋白别名: epididymis luminal protein 215; epididymis secretory sperm binding protein Li 54e; gastric cancer susceptibility protein; OTTHUMP00000165765; OTTHUMP00000165766; OTTHUMP00000220103; OTTHUMP00000220170; OTTHUMP00000220171; PHB; prohibitin; Prohibitin 1; unnamed protein product
基因别名: BAP32; HEL-215; HEL-S-54e; PHB; PHB1
UniProt ID: (Human) P35232, (Rat) P67779
Entrez Gene ID: (Pig) 100524707, (Human) 5245, (Rat) 25344